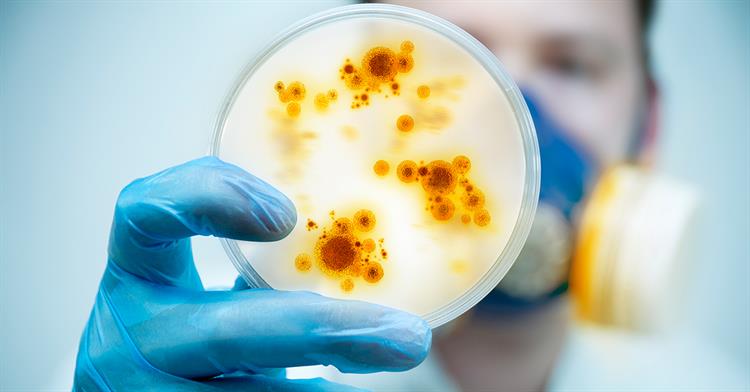
csginc11's tweet image. Schools are well known for their ability to spread germs and illnesses. However, with the right tech it can be easier than ever to rid the facility of germs. Read on: bit.ly/302So75 #facman

CSG, Inc
@csginc11
Facility Services custom designed to meet your high standards and do It consistently. Nationwide Cleaning and Building Maintenance. Dennis O'Brien, CEO
You might like
We're one of the top #facman in the industry. Here's why: - Our customer service blueprint works - We maintain high-quality control - We give clients real-time access to service tracking, scheduling, and more - We provide active monitoring bit.ly/2F6fQSW

Is your commercial cleaning service doing a lousy job? Often the service that bids the least is the one that will only give you substandard cleaning. CSG offers you affordable cleaning that's consistently top quality! bit.ly/2F6fQSW #facman

Comprehensive background checks, "train the trainer" programs, and more -- these are just a few ways we're different from other commercial cleaning businesses. bit.ly/2GTiIZ3

When improperly mixed, cleaning chemicals can cause serious damage to employees. Make sure your commercial cleaning crew knows how to properly handle cleaning chemicals: bit.ly/31l4WDf #commercialcleaning
We hire the right people, use the right tools for the job, and pride ourselves on consistency and quality. Learn why we're the #commercialcleaning partner you should turn to: bit.ly/2GNy4Zt

Facility managers are arguably at the front line of helping building owners cut operating costs. So, it's important for the #facman to consider these great steps for doing just that without sacrificing quality in building care: bit.ly/2Pkgxlp

Maintaining your building's HVAC system doesn't just keep occupants comfortable; it can help keep indoor air quality at an optimum level for health and safety. Here are the fundamentals that all facility managers need to know: bit.ly/2lM2wPu #facman #HVAC
Every facility manager wants to cut back on costs. One way to do that is to keep on top of maintenance. Don't overlook the small details. More tips: bit.ly/2Pkgxlp #facman
Schools are well known for their ability to spread germs and illnesses. However, with the right tech it can be easier than ever to rid the facility of germs. Read on: bit.ly/302So75 #facman
All facility managers should be concerned with cutting costs, but the right approach means you don't have to cut corners or quality. Here's how to get it right: bit.ly/2Pkgxlp #facman

As a facility manager, are you looking for ways to cut costs without sacrificing quality? Start by reducing reactive maintenance needs. For more information about how to do that, visit this page: bit.ly/2Pkgxlp #facman

It's never cheap to manage your facility, but cutting costs doesn't have to mean cutting quality. Find out how to save without sacrificing: bit.ly/2Pkgxlp
Restrooms, trash cans, sidewalks, and more -- is your cleaning crew paying close attention to these areas of your grocery store? Find out why they should be: bit.ly/2GkmPup
Universal Studios has come up with a new, innovative way to help sanitize things like 3D and virtual reality glasses. Learn why these items are taking a ride: bit.ly/2KWnaVr #commercialcleaning

Arm yourselves with a team that delivers tangible outcomes and measurable results. Learn more about our commercial cleaning services and how to start working with our team: bit.ly/2pEJc4N #cleaningservices

Retailers may not realize it, but customers routinely check for cleanliness in stores, and if your store doesn't meet their expectations, they'll shop somewhere else: bit.ly/2GkmPup #cleaning #facman

Your grocery store can't afford to ignore cleanliness. It's a must in the business. And it extends beyond the aisles. Are your sidewalks neat and clean? bit.ly/2GkmPup #Facman

There's nothing worse than a customer walking into your grocery store and being met with grime, stickiness, and dust everywhere -- that's sure to send them right back out the door. Learn why #grocery cleanliness is crucial: bit.ly/2GkmPup #cleaning
Although it's not a conversation that everyone is comfortable having, it's important for facilities managers and cleaning crews to provide all visitors with access to feminine hygiene products: bit.ly/30DZTxJ

Hard floor care should be a priority for many reasons including public perception and workplace safety. CSG uses specialized techniques for each type of hard flooring. bit.ly/2FBCova #facman

United States Trends
- 1. #GMMTV2026 548K posts
- 2. MILKLOVE BORN TO SHINE 82K posts
- 3. #WWERaw 77K posts
- 4. Finch 14.6K posts
- 5. Purdy 28.4K posts
- 6. TOP CALL 9,262 posts
- 7. AI Alert 8,042 posts
- 8. Moe Odum N/A
- 9. Bryce 21.3K posts
- 10. Timberwolves 3,895 posts
- 11. Keegan Murray 1,536 posts
- 12. Alan Dershowitz 2,723 posts
- 13. Barcelona 136K posts
- 14. Check Analyze 2,412 posts
- 15. Gonzaga 4,118 posts
- 16. Token Signal 8,578 posts
- 17. Panthers 37.8K posts
- 18. Dialyn 7,708 posts
- 19. Enemy of the State 2,589 posts
- 20. Canales 13.5K posts
Something went wrong.
Something went wrong.






















































































































